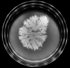

3D Models of 4D Processes from ‘2D’ Petris, 2019
The temporal component of the structure of lifeforms through both space and time often becomes abstract and elusive when overly quantified and graphed. To work towards demystifying the spatiotemporal structure of a small colony of organisms, I created a method through ImageJ and Adobe Photoshop which turns a time-lapse movie of ‘2D’ bacterial growth in a Petri dish, into a static 3D volume, by stacking image slices from the movie. This provides an example of capturing the full temporal component of a multicellular structure.
Examples on right are from Petri time lapses taken by Soonhee Moon (http://daninolab.nyc). Left example is a volume composed of a time lapse from “A Synchronized Quorum of Genetic Clocks”, Danino T, et al. Nature (2010).
‘2D’
A
3D
B
‘2D’
A
3D
B